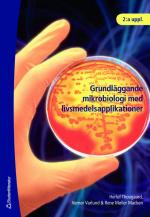
Grundläggande mikrobiologi med livsmedelsapplikationer

- Totalt 0 kr
Grundläggande mikrobiologi med livsmedelsapplikationer
Lägg till en bevakning så meddelar vi dig så snart varan är i lager igen.
Grundläggande mikrobiologi med livsmedelsapplikationer
Upplaga: 2
Kurskoder: YTHA73 YTHF35
Författare: Thougaard, Varlund, Møller-Madsen
ISBN: 9789144006567
Artikelnummer: 153001